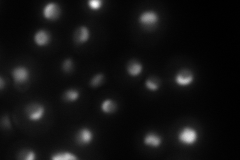
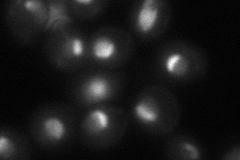

View description
Putative ATP-dependent RNA helicase of the DEAD-box family involved in ribosomal biogenesis
Localization:
Intensity:
Fold change:
Significance:
-
C’ GFP library in SD

nucleolus111.55 -
N' NOP1pr-GFP in SD

nucleolus149.522 -
N' TEF2pr-mCherry in SD
nucleus,nucleolus139.074 -
N' NATIVEpr-GFP in SD

nucleolus89.3873 -
N' TEF2pr-VC and Cyto-VN in SD
nucleus,nucleolus58.1074 -
C’ GFP library in SD+DTT

nucleolus81.320.72No -
C’ GFP library in SD+H2O2

nucleolus115.051.03No -
C’ GFP library in Starvation Media

nucleolus21.230.19Yes -
C’ GFP library on the background of Pup2-DaMP

nucleolus -
C’ GFP library on the background of CCT mutant

nucleolus127.1631.13992No
